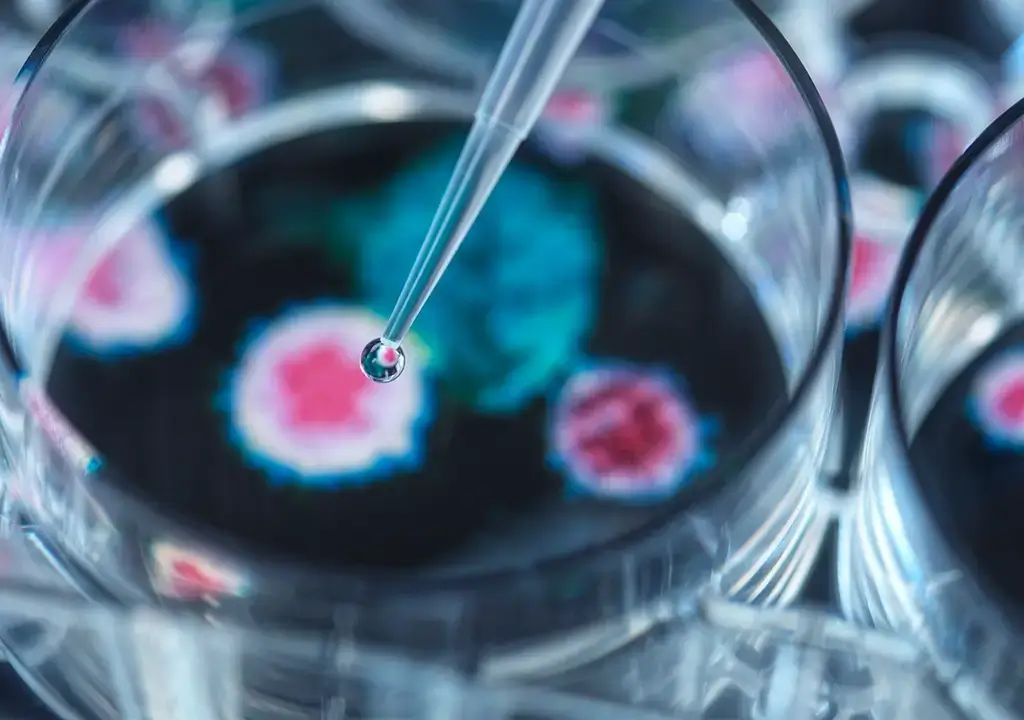

WHY CHOOSE US?
The Gateway to the World's Most Advanced Therapies
The concept of the Stem Cell Sports Institute was founded by Rakel Apodaca, an internationally recognized pioneering force in functional medicine and stem cell research. Rakel Apodaca is also the founder of Kalbio Biotechnology, the only FDA-IND authorized supplier of minimally manipulated umbilical cord blood stem cells for regenerative use for research purposes in the United States. Her leadership places the Stem Cell Sports Institute at the forefront of medical innovation, setting the global standard for advanced regenerative protocols.
Unlike conventional clinics, the Institute is directly connected to the highest levels of research and application. The same regenerative biologics utilized by U.S. Military Special Forces, elite athletes, and private research institutions form the foundation of the Institute’s therapies. This unique position ensures that every patient receives access to science and technology trusted by some of the most demanding and discerning organizations in the world.
Patients choose the Stem Cell Sports Institute because it represents more than treatment — it represents transformation. From pediatrics and rare conditions to cancer, chronic illness, and sports recovery, the Institute delivers cutting-edge regenerative medicine, frequency-based therapies, and functional medicine programs designed to achieve what others cannot. For those seeking the most advanced care available anywhere, the Stem Cell Sports Institute stands alone. Just wait till you meet the medical team!

Expert Medical Team
Our board-certified physicians and experienced clinical staff combine decades of sports medicine and cellular therapy expertise. Every treatment plan is customized to your goals, medical history, and lifestyle.
Your Partner in Regenerative Wellness
• Ethically Sourced Stem Cells – Partnering with trusted suppliers like Kalbio for safety, purity, and compliance.
• Athlete-Focused, Patient-Centered – Customized treatments for faster recovery, pain relief, and peak performance.
• State-of-the-Art Facility – Modern technology, strict sterile protocols, and a comfortable spa-like setting.
• Transparent Guidance & Support – Clear communication from consultation to follow-up so you always know what to expect.
Start Your Journey With Stem Cell Sports Institute
Recover faster, ease pain, and boost performance with advanced stem cell therapies. Our team will answer your questions and create a plan built just for you.
• Personal Consultation
• Customized Plan
• Access to Advanced Therapies
• Guidance Every Step
• Compassionate Care

Ready to Begin Your Recovery Journey?
Take the first step toward faster healing, better performance, and long-term wellness with Stem Cell Sports Institute.
Our team is here to answer your questions and create a plan tailored to you.
Let’s unlock the power of regenerative medicine together.

